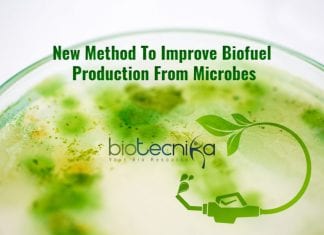
ICGEB Scientists’ New Method To Boost Biofuel Sector biofuel from bacteria

Biotecnika Times – Newsletter 09.03.2020 – Google PhD Fellowship, Govt Pollution...
Biotecnika Times - Google PhD Fellowship, Govt Pollution Control Board
DBT-Research Associateship in Biotech & Life Sciences 2020 – Applications Invited
DBT RA Program 2020 –...
This Women’s Day We Salute All Women CSIR NET Toppers Of...
Women CSIR NET Toppers of Biotecnika - Happy Women's Day
Women - Be it a mother, daughter sister or wife always have supported us &...
IISER TVM PhD & Integrated PhD Admission 2020 – Biological Sciences
IISER TVM Admission 2020 (PhD & Integrated PhD) - Biological Sciences
IISER TVM Admission 2020 (PhD & Integrated PhD) - Biological Sciences. The notification for...
Team of Indian Scientists Develop New Diagnostics for Asymptomatic Malaria
Diagnostics for Asymptomatic Malaria
Bengaluru-based Jigsaw Bio Solutions and the Department of Biotechnology’s Bhubaneswar-based Institute of Life Sciences (ILS) formed a joint team of scientists...
11 Eminent Indian Women Scientists The STEM Chairs Are Named After
Chairs In Institutes Across India, Honoring Eminent Women Scientists
After the Indian government has decided to establish chairs in institutes in the name of prominent...
For First Time Ever CRISPR Editing Done In Live Patient
First Direct Use Of CRISPR In Humans By Harvard Doctors
Scientists edited the DNA inside a living human being for the first time ever....
Coronavirus Patients Globally Recovering At High Rates – John Hopkins Study
Coronavirus Patients Recovered
Globally, more than half of infected patients are recovered
As the coronavirus outbreak has been spreading increasing, we have been concerned and worried...
Biotecnika Times – Newsletter 06.03.2020 – Govt CSIR-CIMAP & URDIP Job,...
Biotecnika Times - Govt CSIR-CIMAP & URDIP Job, KV Maharashtra Job
Govt CSIR-CIMAP Biotech & Life Science Job With Rs. 98,465 pm Salary
CIMAP Jobs –...
Georgetown University Master’s Degree in Bioinformatics Admission 2020
Georgetown University Bioinformatics Admission 2020 - Apply Online
Georgetown University Bioinformatics Admission 2020 - Apply Online. Interested and eligible applicants can check out all of...
Summer Internship For Post-graduate Students at Madurai Kamaraj University
Summer Internship Life Science at Madurai Kamaraj University
Summer Internship Life Science at Madurai Kamaraj University. Summer Internship For Life Science Post-graduate Students at Madurai...
New Cas9 Variant To Increase Efficiency Of CRISPR
New Cas9 Variant With Improved Accuracy In CRISPR Discovered
CRISPR-Cas9 is a unique technology that revolutionized genetics through its ability to edit the genome. It...
ICGEB Scientists’ New Method To Boost Biofuel Sector
Biofuel From Bacteria - Scientists' New Study Could Boost Biofuel Sector
Scientists at the International Centre for Genetic Engineering and Biotechnology (ICGEB) developed a...
Promoting Pigmentary Disorders Research Through Rs. 3.6 crore Research Grant
Rs. 3.6 crore Research grant for pigmentary disorders
With the Wellcome Trust/DBT India Alliance conferring an Intermediate Fellowship Award on an Assistant Professor at Faridabad-based...
HIV-Like Mutation In Coronavirus Explains It’s Highly Infectious Nature
Coronavirus Is Similar To HIV In Infection Pathway
According to the new research by scientists in China and Europe, the new coronavirus has an HIV-like...
Coronavirus Pandemic – Stark Reminder Why We Must Promote Life Sciences...
Coronavirus Pandemic - Global Impact of Coronavirus Outbreak
A Stark Reminder Why We Must Promote Life Sciences Research
Novel Coronavirus - Covid-19
Edging towards pandemic levels, the...
IBAB Admissions 2020 – MSc Biotechnology & Bioinformatics
IBAB Admissions 2020 - MSc Biotechnology & Bioinformatics
ABOUT IBAB
education, research & entrepreneurship. Located on a sprawling 20-acre campus in the south of Bengaluru, the...
IIT Madras Research Admission July 2020 – Applications Invited
IIT Madras Admission 2020 For Research - Applications Invited
IIT Madras Research Admission July 2020 - Applications Invited. PhD / Direct PhD / MSc Admissions...
Biotecnika Times – Newsletter 05.03.2020 – Govt Silk Board Job, J...
Biotecnika Times - Govt Silk Board Job, J N Tata Scholarship, KV Punjab
CSIR Shanti Swarup Bhatnagar Prize for Science and Technology 2020
Shanti Swarup Bhatnagar...
Biotecnika Times – Newsletter 04.03.2020 – JNUEE 2020-21 Exam, State Biodiversity...
Biotecnika Times - JNUEE 2020-21 Exam, State Biodiversity Board Job
JNUEE 2020-21 Exam – Jawaharlal Nehru University Entrance Examination
JNUEE 2020-21 Exam Notification – Jawaharlal Nehru...
Egg Stem Cells Do Not Exist – New Findings
After analyzing all cell types in the human ovary, the researchers at Karolinska Institutet in Sweden have shed new insights into developmental biology. According...